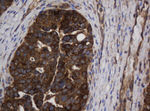
ASGR2 Antibody in Immunohistochemistry (Paraffin) (IHC (P))

Search
OriGene
ASGR2 Monoclonal Antibody (OTI2A12), TrueMAB™
{{$productOrderCtrl.translations['antibody.pdp.commerceCard.promotion.promotions']}}
{{$productOrderCtrl.translations['antibody.pdp.commerceCard.promotion.viewpromo']}}
{{$productOrderCtrl.translations['antibody.pdp.commerceCard.promotion.promocode']}}: {{promo.promoCode}} {{promo.promoTitle}} {{promo.promoDescription}}. {{$productOrderCtrl.translations['antibody.pdp.commerceCard.promotion.learnmore']}}
产品信息
CF505099
种属反应
宿主/亚型
分类
类型
克隆号
抗原
偶联物
形式
浓度
纯化类型
保存液
内含物
保存条件
运输条件
产品详细信息
For reconstitution, we recommend adding 100 µL distilled water to a final antibody concentration of about 1 mg/mL. To use this carrier-free antibody for conjugation experiments, we strongly recommend performing another round of desalting. (Zeba Spin Desalting Columns, 7KMWCO, 0.5 mL, Product # 89882)
靶标信息
ASGR2 is a cell surface receptor that binds to galactose-terminated glycoproteins. It transports these glycoproteins via a series of membrane vesicles and tubules to an acidic-sorting organelle where the receptor and ligand dissociates. Then the receptor is recycled back to the cell surface. There are four alternatively spliced transcript variants of this gene. This gene has multiple polyadenylation sites.
仅用于科研。不用于诊断过程。未经明确授权不得转售。
篇参考文献 (0)
生物信息学
蛋白别名: ANCO-2; ANCO1; ASGP-R 2; Asialoglycoprotein receptor 2; C-type lectin domain family 4 member H2; GAC-1; HBxAg-binding protein; Hepatic lectin H2; HL-2; Nbla00144
基因别名: ASGP-R2; ASGPR2; ASGR2; CLEC4H2; HBXBP; HL-2
UniProt ID: (Human) P07307
Entrez Gene ID: (Human) 433